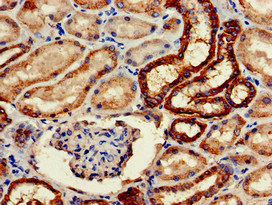

WWP2 Antibody
-
中文名稱:WWP2兔多克隆抗體
-
貨號:CSB-PA026168LA01HU
-
規格:¥440
-
圖片:
-
其他:
產品詳情
-
產品名稱:Rabbit anti-Homo sapiens (Human) WWP2 Polyclonal antibody
-
Uniprot No.:
-
基因名:
-
別名:WWP2NEDD4-like E3 ubiquitin-protein ligase WWP2 antibody; EC 2.3.2.26 antibody; Atrophin-1-interacting protein 2 antibody; AIP2 antibody; HECT-type E3 ubiquitin transferase WWP2 antibody; WW domain-containing protein 2 antibody
-
宿主:Rabbit
-
反應種屬:Human
-
免疫原:Recombinant Human NEDD4-like E3 ubiquitin-protein ligase WWP2 protein (145-367AA)
-
免疫原種屬:Homo sapiens (Human)
-
標記方式:Non-conjugated
本頁面中的產品,WWP2 Antibody (CSB-PA026168LA01HU),的標記方式是Non-conjugated。對于WWP2 Antibody,我們還提供其他標記。見下表:
-
克隆類型:Polyclonal
-
抗體亞型:IgG
-
純化方式:>95%, Protein G purified
-
濃度:It differs from different batches. Please contact us to confirm it.
-
保存緩沖液:Preservative: 0.03% Proclin 300
Constituents: 50% Glycerol, 0.01M PBS, pH 7.4 -
產品提供形式:Liquid
-
應用范圍:ELISA, IHC
-
推薦稀釋比:
Application Recommended Dilution IHC 1:20-1:200 -
Protocols:
-
儲存條件:Upon receipt, store at -20°C or -80°C. Avoid repeated freeze.
-
貨期:Basically, we can dispatch the products out in 1-3 working days after receiving your orders. Delivery time maybe differs from different purchasing way or location, please kindly consult your local distributors for specific delivery time.
-
用途:For Research Use Only. Not for use in diagnostic or therapeutic procedures.
相關產品
靶點詳情
-
功能:E3 ubiquitin-protein ligase which accepts ubiquitin from an E2 ubiquitin-conjugating enzyme in the form of a thioester and then directly transfers the ubiquitin to targeted substrates. Polyubiquitinates POU5F1 by 'Lys-63'-linked conjugation and promotes it to proteasomal degradation; in embryonic stem cells (ESCs) the ubiquitination is proposed to regulate POU5F1 protein level. Ubiquitinates EGR2 and promotes it to proteasomal degradation; in T-cells the ubiquitination inhibits activation-induced cell death. Ubiquitinates SLC11A2; the ubiquitination is enhanced by presence of NDFIP1 and NDFIP2. Ubiquitinates RPB1 and promotes it to proteasomal degradation.
-
基因功能參考文獻:
- The present study suggested that miR32 may effectively inhibit WWP2 expression in human amniotic epithelial stem cells and promote Oct4 overexpression to maintain their pluripotency. PMID: 29393344
- Our study suggests that WWP2 may play a role in the genesis and development of glioma; it may be a potential biomarker to predict pathological grade and tumor recurrence in patients with glioma. PMID: 29237971
- SNP rs62051384, located within WWP2, showed an association with plantar fascial disorders at genome-wide significance (p<5x10(-8)) with small effects (odds ratios=0.93 and 1.07 per allele, respectively). PMID: 29534260
- Describe an autoinhibitory mechanism for WWP2 ubiquitin ligase involving a linker-HECT domain interaction. This intramolecular interaction traps the HECT enzyme in its inactive state and can be relieved by linker phosphorylation. PMID: 28475870
- results provide evidence that WWP2 serves as a positive regulator of osteogenesis by augmenting RUNX2 transactivation in a non-proteolytic mono-ubiquitination manner. PMID: 28500134
- Data suggest that elevated expression of WW domain containing E3 ubiquitin protein ligase 2 (WWP2) may play a role in facilitating the development of lung adenocarcinoma. PMID: 27462019
- we demonstrate that WWP2 promotes cell adhesion, invasion, and migration in liver cancer by upregulating CXCR3 and CCR5 expression associated with the chemokine signaling pathway. PMID: 26662306
- WWP2 may represent a novel diagnostic marker and molecular therapeutic target for liver cancer. PMID: 26783238
- majority of ovarian carcinomas harbored homozygous or heterozygous deletions in WWP2 locus, and there was an inverse correlation in the expression levels between WWP2 and Notch3 in ovarian carcinomas PMID: 25356737
- Results identify WWP2 as a novel p73-associated protein that ubiquitinates and degrades p73. PMID: 25071155
- Wwp2 acts as a ubiquitin ligase of SRG3. PMID: 24365151
- WWP2-N is downregulated in stage IIIC melanoma and up-regulated in stage II/III prostate cancer, and WWP2-FL and WWP2-C overexpression is associated with early-stage breast cancer. PMID: 23938591
- Koala retrovirus Gag PPPY L-domain interacts with the WW domain(s) of WWP2 and progeny virions are released from cells by utilizing the multivesicular body sorting pathway. PMID: 23651516
- WWP2 controls cellular apoptosis and is required for tumorigenicity of cells PMID: 21532586
- Data show that the WWP2-N isoform interacts with Smad2 and Smad3, whereas WWP2-C interacts only with Smad7. PMID: 21258410
- expression, binding, and functional data all suggest that WWP2 is a candidate to regulate ENaC-mediated Na(+) transport in epithelia PMID: 12167593
- First demonstration of ubiquitin-protein ligase WWP2 from human lung cDNA library recruited by penton base proteins of adenovirus serotypes Ad2 and Ad3 in vitro and in vivo. PMID: 12450395
- Data show that WWP2 and Nedd4-2 both bind to the cardiac sodium channel Na(v)1.5, but only Nedd4-2 robustly ubiquitinated and downregulated Na(v)1.5. PMID: 15548568
- cIAP1 and cIAP2 promote cancer cell survival by functioning as E3 ubiquitin ligases that maintain constitutive ubiquitination of the RIP1 adaptor protein. PMID: 18570872
- The WWP2 protein is an important regulator for maintaining a proper POU5F1 protein level in human Embryonic Stem Cells. PMID: 19274063
- AIP2 regulates activation-induced T-cell death by suppressing EGR2-mediated FasL expression via the ubiquitin pathway PMID: 19651900
顯示更多
收起更多
-
亞細胞定位:Nucleus.
-
組織特異性:Detected in heart, throughout the brain, placenta, lung, liver, muscle, kidney and pancreas. Also detected in spleen and peripheral blood leukocytes.
-
數據庫鏈接:
Most popular with customers
-
-
YWHAB Recombinant Monoclonal Antibody
Applications: ELISA, WB, IHC, IF, FC
Species Reactivity: Human, Mouse, Rat
-
Phospho-YAP1 (S127) Recombinant Monoclonal Antibody
Applications: ELISA, WB, IHC
Species Reactivity: Human
-
-
-
-
-